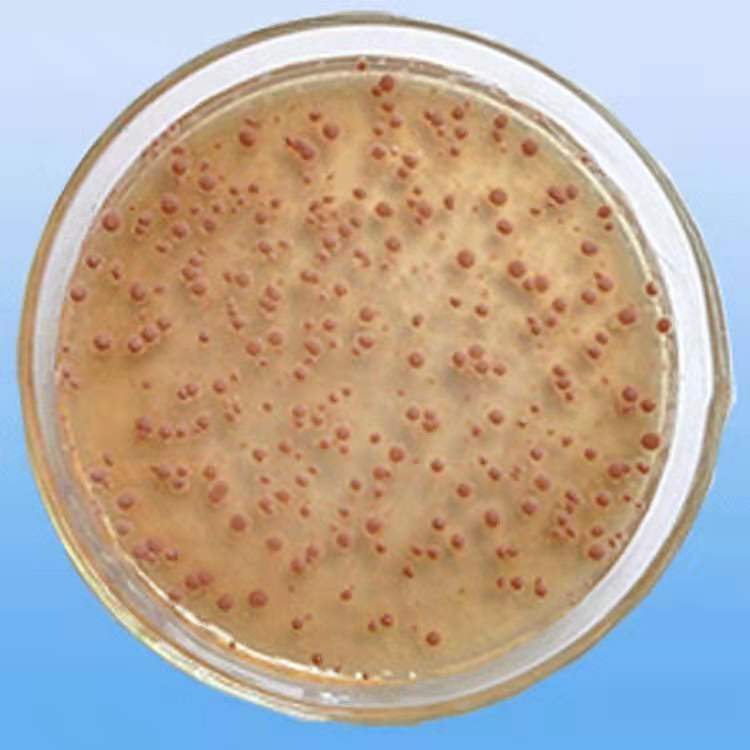

1688
おすすめ商品
1688
すべて
すべて
デジタル、パソコン
住宅建材
ホーム日用品
スポーツアウトドア
ファッションアクセサリー
オフィス用品、文化用品
パッケージ
ホームテキスタイル
子供服
下着
母子用品
おもちゃ
メンズファッション
レディースファッション
シューズ
レザーグッズ、バッグ
ペットと園芸
カー用品
スポーツウェア
個の保護/家清
日用調理器具
収納清掃用具
「B2meのご提案」
1688以外のサイト、現地商品市場から弊社が独自にリサーチした商品のご提案を行います。 また、お取り組み先にご覧頂きやすいように「G/M」が付いた品番はこちらから検索ください。
メニュー
1688